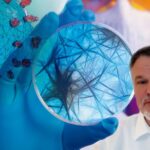
lanka viry neexistují

Výbuchy sopky na ostrově La Palma sílí. Video zachycuje moment mohutného výbuchu s tlakovou vlnou. (Foto: Youtube)Další tři města byla evakuována a hasiči se museli stáhnout kvůli pokračujícím sopečným výbuchům na španělském ostrově La Palma.Návrat sopečné činnosti také přiměl letecké společnosti zrušit lety kvůli "velkému" mraku plynu a popela, který je považován za největší od …
Výbuchy sopky na ostrově La Palma zesilují. Video s tlakovou vlnou

Výbuchy sopky na ostrově La Palma sílí. Video zachycuje moment mohutného výbuchu s tlakovou vlnou. (Foto: Youtube)
Další tři města byla evakuována a hasiči se museli stáhnout kvůli pokračujícím sopečným výbuchům na španělském ostrově La Palma.
Návrat sopečné činnosti také přiměl letecké společnosti zrušit lety kvůli „velkému“ mraku plynu a popela, který je považován za největší od nedělní erupce sopky.
Úřady v pátek nařídily evakuaci měst Tajuya, Tacande de Abajo a části Tacande de Arriba, která ještě nebyla vyklizena.
Obyvatelům těchto míst bylo původně doporučeno zůstat doma, aby je nezasáhl popel a úlomky lávy, ale záchranné služby Kanárských ostrovů se rozhodly toto rozhodnutí změnit, jakmile bylo jasné, že se situace nestabilizovala.
Odebírejte náš newsletter
Zůstaňte v kontaktu s novinkami